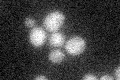
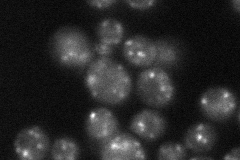

View description
Golgi membrane protein with similarity to mammalian CASP; genetic interactions with GOS1 (encoding a Golgi snare protein) suggest a role in Golgi function
Localization:
Intensity:
Fold change:
Significance:
-
C’ GFP library in SD
below threshold16.28 -
N' NOP1pr-GFP in SD

punctate53.1701 -
N' TEF2pr-mCherry in SD

punctate58.3458 -
N' NATIVEpr-GFP in SD
punctate42.5415 -
N' TEF2pr-VC and Cyto-VN in SD

punctate46.5194 -
C’ GFP library in SD+DTT

cytosol19.171.17No -
C’ GFP library in SD+H2O2

cytosol21.31.3No -
C’ GFP library in Starvation Media

cytosol15.360.94No -
C’ GFP library on the background of Pup2-DaMP

below threshold -
C’ GFP library on the background of CCT mutant

below threshold17.48251.07322No
